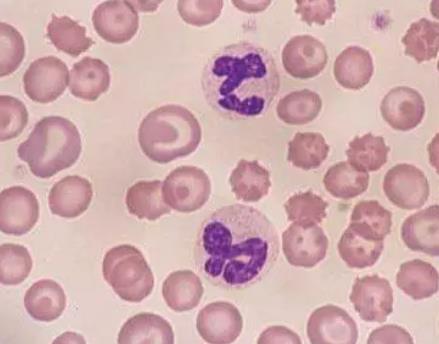
大鼠外周血中性粒细胞

ChemicalBook CAS数据库列表 大鼠外周血中性粒细胞
大鼠外周血中性粒细胞
- CAS号:
- 英文名:Rat peripheral blood neutrophils
- 中文名:大鼠外周血中性粒细胞
- CBNumber:CB95524906
- 分子式:
- 分子量:0
- MOL File:Mol file
大鼠外周血中性粒细胞性质、用途与生产工艺
-
简介
大鼠外周血中性粒细胞采用密度梯度离心法制备而来,细胞纯度可达90%以上,且不含有HIV-1、HBV、HCV、支原体、细菌、酵母和真菌等。
- 细胞简介 大鼠外周血中性粒细胞分离自外周血;外周血是除骨髓之外的血液,临床上常用一些方法把骨髓中的造血干细胞释放到血液中,再在从血液中提取分离得到造血干细胞,我们把这样得到的干细胞称为外周血干细胞,在二十一世纪初人类开始的生命方舟计划中首次提出外周血这一新概念。白细胞是一类无色、球形、有核的血细胞。白细胞不是一个均一的细胞群,根据其形态、功能和来源部位可以分为三大类:粒细胞、单核细胞和淋巴细胞,其中粒细胞又可根据胞质中颗粒的染色性质不同,分为中性粒细胞、嗜酸粒细胞和嗜碱粒细胞三种。中性粒细胞是在瑞氏(Wright)染色血涂片中,胞质呈无色或极浅的淡红色,有许多弥散分布的细小的(0.2-0.4微米)浅红或浅紫色的特有颗粒。细胞核呈杆状或2-5分叶状,叶与叶间有细丝相连。中性粒细胞具趋化作用、吞噬作用和杀菌作用。中性粒细胞来源于骨髓,具有分叶形或杆状的核,胞浆内含有大量既不嗜碱也不嗜酸的中性细颗粒。这些颗粒多是溶酶体,内含髓过氧化酶、溶菌酶、碱性磷酸酶和酸性水解酶等丰富的酶类,与细胞的吞噬和消化功能有关。中性粒细胞在血液的非特异性免疫中起着十分重要的作用,它处于机体抵御微生物病原体,特别是在化脓性细菌入侵的第一线,具有很强的吞噬活性,可吞噬细菌、衰老的红细胞、抗原一抗体复合物和坏死的细胞等。中性粒细胞内含有大量溶酶体酶,因此能将吞噬入细胞内的细菌和组织碎片彻底分解。当中性粒细胞吞噬数十个细菌后,自身发生解体,所释出的各种溶酶体酶类能溶解周围组织而形成脓液。中性粒细胞是人体内寿命最短的细胞,一般体外培养12-24 h内活性稳定,48 h活性下降,96 h基本死亡。
- 用途 大鼠外周血中性粒细胞可用于大鼠外周血中性粒细胞在较长细菌刺激时期内的生物学反应特性及其意义研究。
- 组织来源 外周血
- 制备方法 大鼠外周血中性粒细胞采用取外周血、通过密度梯度离心法制备而来。
大鼠外周血中性粒细胞上下游产品信息
上游原料
下游产品
大鼠外周血中性粒细胞生产厂家
- 公司名称:上海沪震实业有限公司
- 联系电话:021-60345367 13916550749
- 电子邮件:sales@shzbio.com
- 国家:中国
- 产品数:9965
- 优势度:58
- 公司名称:柯依博(上海)科技有限公司
- 联系电话:201-52273538 15316728970
- 电子邮件:carebroad@163.com
- 国家:中国
- 产品数:3289
- 优势度:58
- 公司名称:上海酶联生物科技有限公司
- 联系电话: 15216759556
- 电子邮件:mlbioname@qq.com
- 国家:中国
- 产品数:6815
- 优势度:58
- 公司名称:武汉普诺赛生命科技有限公司
- 联系电话: 4009992100
- 电子邮件:sales@procell.com.cn
- 国家:中国
- 产品数:4855
- 优势度:58
- 公司名称:青旗(上海)生物技术发展有限公司
- 联系电话:021-4006560232 4006560232
- 电子邮件:cellsupport@bluefcell.com
- 国家:中国
- 产品数:2041
- 优势度:58
- 公司名称:广州创择生物科技有限公司
- 联系电话:18312220236
- 电子邮件:
- 国家:中国
- 产品数:6078
- 优势度:58
- 公司名称:广州吉必酷生物科技有限公司
- 联系电话:15820270369
- 电子邮件:
- 国家:中国
- 产品数:6224
- 优势度:58
- 公司名称:广州三询生物科技有限公司
- 联系电话:15626124417
- 电子邮件:
- 国家:中国
- 产品数:6687
- 优势度:58
- 公司名称:重庆奥怡生物技术有限公司
- 联系电话:13102311730,18585291730
- 电子邮件:
- 国家:中国
- 产品数:6240
- 优势度:58
- 公司名称:深圳赛杰生物科技有限公司
- 联系电话:02087223099
- 电子邮件:
- 国家:中国
- 产品数:6486
- 优势度:58
大鼠外周血中性粒细胞相关搜索:
